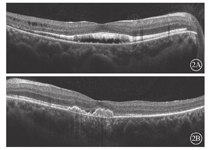

版权归中华医学会所有。
未经授权,不得转载、摘编本刊文章,不得使用本刊的版式设计。
除非特别声明,本刊刊出的所有文章不代表中华医学会和本刊编委会的观点。
患者女,26岁。因左眼视物变形1个月于2018年9月17日到上海和平眼科医院就诊。患者3年前于外院诊断为"双眼闭角型青光眼",并行双眼YAG激光虹膜周边切除手术。否认家族遗传病史,其母视力及眼底检查正常,其父视力正常。10多岁时发现夜盲。患者一般情况良好。眼科检查:右眼视力1.0;左眼视力0.6,矫正不能提高。双眼屈光度均为+0.5 DS。右眼、左眼眼压分别为30、28 mmHg (1 mmHg=0.133 kPa)。双眼眼轴长度均为21 mm。双眼眼前节正常,前房浅,上方虹膜周切口通畅。晶状体透明,玻璃体不混浊。双眼视盘边界清楚,C/D为0.8;视网膜血管未见明显异常。双眼视网膜后极部不均匀黄白色物质沉积,黄斑中心凹反光消失(图1)。频域OCT (SD-OCT)检查,右眼内核层层间劈裂,外界膜下椭圆体带、光感受器外节大量强反射物质沉积,RPE/Bruch膜上锥形强反射物质沉积,两层强反射之间有弱反射暗区(空腔);左眼黄斑中心凹RPE下强反射隆起,Bruch膜断裂(图2)。OCT血管成像(OCTA)检查,右眼脉络膜毛细血管层大片血流信号遮蔽成暗区,其内及边缘见小片状非血流信号团;左眼无脉管层暗区内见线团状异常血流信号团(图3)。FFA检查,右眼黄斑中心凹旁斑片状强荧光,晚期染色;左眼晚期黄斑鼻下方三角形强荧光素渗漏(图4)。FAF检查,双眼后极部斑点状环形强荧光,累及颞侧及下方视网膜(图5)。EOG检查,双眼光峰值降低或消失,右眼、左眼Arden比值分别为1.2、1.1。诊断:双眼常染色体隐性卵黄样黄斑营养不良(ARB );左眼脉络膜新生血管(CNV)。患者于复旦大学附属眼耳鼻喉科医院行基因检测,提示BEST1基因杂合突变,突变位点c.140G> A,氨基酸变化p.R47H。给予双眼降眼压药物治疗;左眼玻璃体腔注射雷珠单抗治疗,每月1次,连续3次。左眼第1次注射后,患者诉视物变形症状消失;视力1.0。随访至今无变化。

BEST1基因相关ARB为少见眼底病变,其起源于RPE基底外侧的BEST1基因发生突变,BEST1基因失去功能,导致RPE及视网膜功能障碍[1,2,3,4,5]。该病好发于儿童及年青人,性别无异。双眼或单眼中心视力下降是主要症状。眼底检查可见黄斑区多个位于视网膜下的黄白色沉着物,可以累及血管弓周围甚至中周部视网膜。病变在FAF检查下显示更为清楚,且数量更多。OCT检查可见视网膜内囊样水肿或黄斑视网膜脱离;RPE上或内见到强反射团块即为黄白色沉着物;视网膜外层椭圆体带可能断裂,RPE也可出现萎缩。OCTA检查可见脉络膜毛细血管层血流信号被卵黄样物质遮蔽形成暗区,在无脉管层清晰显示暗区内线团状的异常血流信号团,即CNV。而FFA上因卵黄样物质染色等原因不易发现新生血管渗漏。这提示,对于ARB患者,OCTA检查更容易清楚发现CNV病灶。既往研究发现,与显性卵黄样黄斑营养不良(BEST病)的正常ERG表现有所不同,ARB患者可能有视锥、视杆细胞振幅降低或潜伏期延长[6]。但本例患者因客观原因未能行ERG检查。其EOG检查可见光峰值降低或消失。本例患者临床及多模式影像检查均符合ARB的眼底特征。
BEST1基因除作用于视网膜外,对眼前节发育亦有影响。患者常伴有浅前房、窄房角,短眼轴、远视等危险因素,易发生闭角型青光眼。本例患者也具有上述眼前节特征。其屈光检查为远视,双眼眼轴21 mm。初诊诊断为闭角型青光眼并行激光虹膜周边切除手术,但因眼压始终未能降至正常又加用了降眼压药物。这可能是因为ARB的高眼压不仅与浅前房、房角关闭有关,可能还涉及到房角发育不全[7,8]。尽管本例患者眼前后节及影像学检查特征均与ARB符合,但我们依然建议其行基因检测并最终确诊为ARB。
目前对于ARB只能针对症状进行治疗。本例患者左眼并发CNV,给予玻璃体腔注射抗VEGF药物治疗后患者自觉视物变形症状消失,视力恢复至1.0。
本例患者的诊治经验提示临床,对于闭角型青光眼的年轻患者,除检查房角外,还应观察眼底并进行相应的影像检查,以早期发现ARB。对已诊断为ARB者,随访中注意观察眼压并及时发现CNV,尽量保全患者视力。
感谢复旦大学附属眼耳鼻喉科医院宣懿医生提供患者基因检测结果
所有作者均声明不存在利益冲突





















